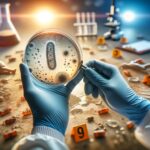
Percée médico-légale : prédire l'heure du décès grâce à la microbiologie SciTechDaily

Selon une étude, le chalutage de fond contribue de manière significative aux émissions atmosphériques de carbone en perturbant les sédiments océaniques. Cette méthode non seulement nuit aux écosystèmes marins, mais libère également de grandes quantités de dioxyde de carbone, doublant ainsi les émissions liées à la consommation de carburant de la flotte de pêche mondiale. Une action politique immédiate est demandée pour lutter contre cette source négligée de pollution par le carbone et atténuer son impact sur le changement climatique et la santé des océans.
Une étude historique a révélé que le chalutage de fond contribue au rejet de jusqu’à 370 millions de tonnes de dioxyde de carbone par an dans l’atmosphère. L’étude souligne que les zones de la mer de Chine orientale, de la mer Baltique, de la mer du Nord et de la mer du Groenland sont les plus importants contributeurs à cet impact environnemental, présentant les plus grandes empreintes climatiques des activités de chalutage.
Les scientifiques ont découvert que le chalutage de fond, une méthode consistant à traîner un lourd filet sur le fond de l’océan, joue un rôle jusqu’alors méconnu dans les émissions de carbone atmosphérique. Dans le cadre des efforts mondiaux visant à réduire les émissions liées aux combustibles fossiles, à la déforestation et à d’autres activités, la recherche met en évidence la contribution du chalutage de fond à la pollution par le carbone en perturbant les sédiments des fonds marins et en libérant du carbone dans l’atmosphère.
Une étude précédente a révélé qu’une partie du carbone des sédiments perturbés se transforme en dioxyde de carbone sous l’eau. L’étude d’aujourd’hui révèle que 55 à 60 % du dioxyde de carbone produit sous l’eau par le chalutage de fond se retrouvera dans l’atmosphère d’ici neuf ans.
On estime que la quantité de carbone rejetée chaque année dans l’atmosphère par le chalutage de fond représente le double des émissions annuelles dues à la combustion de carburants de l’ensemble de la flotte de pêche mondiale, soit environ 4 millions de navires.
Les effets environnementaux et climatiques du chalutage de fond
« Nous savons depuis longtemps que traîner de lourds filets de pêche – certains aussi gros que dix avions 747 – sur le fond de l’océan détruit la vie marine et ses habitats », a déclaré le Dr Trisha Atwood de l’Université d’État de l’Utah et du National Geographic Pristine Seas.
« Ce n’est que récemment que nous avons découvert que le chalutage de fond libère également des panaches de carbone qui, autrement, seraient stockés en toute sécurité pendant des millénaires dans le fond océanique. Notre étude est la toute première à montrer que plus de la moitié du carbone rejeté par le chalutage de fond finit par s’échapper dans l’atmosphère sous forme de dioxyde de carbone sur une période d’une dizaine d’années, contribuant ainsi au réchauffement climatique. Tout comme la destruction des forêts, le grattage des fonds marins cause des dommages irréparables au climat, à la société et à la faune.
L’étude a été menée par une équipe mondiale d’experts du climat et des océans de l’Utah State University, NASA Goddard Institute for Space Studies, Université de Californie à Santa Barbara, Université de ColombieUniversité James Cook et National Geographic Pristine Seas.
Les chercheurs ont utilisé des données sur le chalutage de fond effectué à l’échelle mondiale entre 1996 et 2020 et des modèles sophistiqués pour calculer la quantité de dioxyde de carbone produit par le chalutage de fond qui finit par pénétrer dans l’atmosphère. Cette étude s’appuie sur des recherches fondamentales récentes qui ont révélé que la quantité de dioxyde de carbone rejetée dans l’océan par le chalutage de fond est supérieure aux émissions annuelles de carbone de la plupart des pays et du même ordre de grandeur que les émissions annuelles de dioxyde de carbone de l’aviation mondiale.
Les points chauds mondiaux et l’urgence d’agir
La nouvelle recherche identifie les zones océaniques où les émissions de carbone dues au chalutage de fond sont particulièrement élevées, notamment la mer de Chine orientale, la mer Baltique, la mer du Nord et la mer du Groenland. Les chercheurs concluent que l’Asie du Sud-Est, le golfe du Bengale, la mer d’Oman, certaines parties de l’Europe et le golfe du Mexique sont également probablement des sources majeures d’émissions de carbone dues au chalutage, mais nous manquons actuellement de données suffisantes sur l’étendue et l’intensité des émissions de fond. chalutage dans ces zones.
« À l’heure actuelle, les pays ne tiennent pas compte des émissions de carbone importantes du chalutage de fond dans leurs plans d’action climatique », a déclaré le Dr Enric Sala, explorateur national en résidence et directeur exécutif de Pristine Seas. « Nos recherches montrent clairement que la lutte contre ces émissions et d’autres émissions océaniques est essentielle pour ralentir le réchauffement de la planète, en plus de restaurer la vie marine. La bonne nouvelle est que la réduction des émissions de carbone provenant du chalutage de fond apportera des avantages immédiats. La mauvaise nouvelle est que retarder l’action garantit que les émissions dues au chalutage continueront de s’infiltrer dans l’atmosphère dans dix ans.
La nouvelle étude évalue également ce qu’il advient du carbone qui reste piégé dans les eaux océaniques après le chalutage de fond. Il conclut qu’entre 40 et 45 % du carbone total délogé du fond des océans par le chalutage reste dans l’eau, conduisant à une plus grande acidification localisée des océans. Cette acidité accrue endommage la vie végétale et animale de la zone où se déroule l’activité de pêche.
« Le chalutage de fond pose bien plus de problèmes que les seuls impacts du carbone, par exemple sur la biodiversité et la durabilité », a déclaré Gavin A. Schmidt, directeur de l’Institut Goddard d’études spatiales de la NASA. « Mais cette « déforestation marine » est suffisamment importante pour être constatée et évaluée. Espérons que cela puisse conduire à des efforts politiques susceptibles de tenter de maximiser les bénéfices sur tous les impacts.